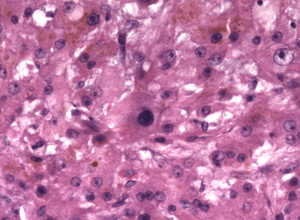
老年低溫症

概述
 老年低溫症
老年低溫症人類是屬於恆溫動物,正常情況下,體溫會保持在37℃,但如果長時間處於寒冷的氣溫之下,又沒有做好防寒準備,或是某些特殊的疾病,導致體內溫度失調,便會讓體溫不斷下降,一旦低於35℃以下,人就會開始變得意識不清、喪失判斷能力、行動變得遲緩,嚴重時還會導致休克昏迷等現象,這就是一般低溫症常見的症狀。
根據美國的統計數據顯示,每年有約七百人會因低溫症而死亡,但是台灣地區卻沒有相關的統計數字,原因多半是在台灣地區所發生的低溫症,除了因災難或是疏忽所造成的死亡,只要能及時發現和治療,其實並不至於會導致不可挽救的後果。
體溫是指機體內部的溫度。正常人腋下溫度為30-37度,口腔溫度比腋下高0.2-0.4度,直腸溫度又比口腔溫度高0.3 -0.5度。
人體的溫度是相對恆定的正常人在24小時內體溫略有波動,一般相差不超過1度。生理狀態下,早晨體度略低,下午略高。運動、進食後、婦女月經期前或妊娠期體溫稍高,而老年人體溫偏低。體溫高於正常稱為發熱,37.5-38度為低熱,38-39度為中度發熱,39-40度為高熱,40度以上為超高熱。人體溫度相對恆定是維持人體正常生命 活動的重要條件之一,如體溫高於41度或低於25度時將嚴重影響各系統(特別是神經系統)的機能活動,甚至危害生命。機體的產熱和散熱,是受神經中樞調節的,很多疾病都可使體溫正常調節機能發生障礙而使體溫發生變化。臨床上對病人檢查體溫,觀罕其變化對診斷疾病或判斷某些疾病的預後有重要意義。
老年人的體溫持續在35℃以下,醫學上便稱作“老人低溫症”。老年人容易罹患此病,是因為身體機能老化,體內產熱減少,能夠覺察到溫度降低的身體機能喪失了敏感度,在與寒冷的接觸中,皮膚血管反應遲鈍,不能很好地收縮,丟失的熱量也比較多,因而不能使體溫維持在一定的水平。老年人冬季低溫症的形成一般需要數天時間。當老人體溫降到35℃、36℃時,一般自己還能訴說寒冷,但有嗜睡、無精打采的症狀。若體溫低於35℃,就可能出現意識障礙,此時老人的皮膚往往蒼白,摸上去有冰涼的感覺,有時還可發現紫癜或水皰,面部腫脹,肌肉僵硬,很少有寒戰反應,會出現呼吸、心率減慢,如不及時採取措施,可以發展到心跳驟停。
預防“老人低溫症”,首先要注意保暖,老人的居室溫度最好保持在20℃左右,睡眠時,床上要採取一些保暖措施,如使用電熱毯、熱水袋等。其次,要多參加一些活動,如散步、打太極拳、做廣播操、種花、養鳥等等。第三,老年人冬季應多進食一些高熱量的食物,但不宜多飲酒。如果體溫一直不能回升,應及時到醫院治療。
三階段
1.發抖、畏寒:身體剛開始感覺到寒冷時,臉色不但會變得蒼白,還會不斷發抖。
2.意識不清:當體溫不斷下降時,發抖的情況反而可能會停止,這時肌肉就會變得僵硬,並且出現神智不清的症狀。
3.昏迷、心跳緩慢或停止:若是情況不斷嚴重下去,患者的血壓會開始降低,心律不整,並且導致心跳停止、昏迷休克,甚至是死亡的結果。
流行病學
 老年低溫症
老年低溫症低溫症分為人為因素和意外性低溫症。後者通常表示非人為的人體深部溫度降低,又分為原發性和繼發性兩類。凡伴有基礎疾病,即處於輕微寒冷環境所引起的低溫症稱為繼發性低溫症,這在老年人中所占比例較大,高齡者尤甚。許多重要的基礎疾病可以繼發低溫症,如重症感染(敗血症出現低溫症是預後不良徵兆)、內分泌疾病、中樞神經和運動系統疾病(腦血管意外、帕金森氏病)、使用藥物和大量飲酒、精神錯亂和痴呆等。
意外性低溫症的診斷包括病史、臨床症狀、查體和實驗室檢查等。老年低溫症患者常因獨居、病史中有夜間下床跌倒暴露於寒冷環境中。有下列徵象者應疑及該病:①面部虛腫、皮膚臘樣蒼白;②肢體震顫;③心律失常、語言不清、呼吸變慢變淺且難以看清;④低血壓;⑤昏睡或陷入昏迷。口腔溫度對測定深部體溫很不可靠,且普通體溫計對最低體溫僅能測量到34.4℃,必要時應採用低讀數體溫計,插入直腸內5cm測溫5分鐘,這是測量體內溫度的常用方法。值得注意的是,當口腔溫度不能升至35℃以上,就應測量老年人的直腸溫度。
病因
 注意保暖
注意保暖2.內在因素 內因對老年低溫症患者極為重要,可分為生理性和病理性原因,即體溫調節的生理功能障礙和伴隨的各種基礎疾病及降低熱能產生的藥物是老年人意外性低溫症的重要病因。
(1)生理性原因:人體溫度能夠保持恆定,是通過生理調節使體內熱量的產生和發散保持平衡人體處於寒冷環境時,機體一方面通過丘腦下部體溫調節中樞使交感神經興奮,心率加快皮膚血管收縮,以保存體熱;另一方面促使肌肉寒戰(即發反應),促進甲狀腺和腎上腺的分泌功能(遲發反應),以增加熱量產生。在老年人上述自主性體溫調節功能發生障礙,表現為皮膚對寒冷的血管收縮反應減退甚至無反應,並出現異常的外周血流型(靜息時外周血流量減少,可<5ml/100ml手部組織/min,而正常人則不減少)。皮膚溫度鑑別能力亦減退,例如,年輕人手指能辨別的溫差<1℃,而老年人手指只能辨別>2℃的溫差,有的甚至溫差在5℃以上尚不能覺察。這種體溫調節的生理性障礙是導致老年人容易發生意外性低溫症的原因。
(2)病理性原因:老年人雖可因處於寒冷環境和體溫調節的生理性障礙引起原發性意外性低溫症,但更多見的則是病理性原因即繼發性低溫症,許多重要的基礎疾病可以繼發低溫症。
①重症感染:敗血症可表現為低溫症而無發熱,而且是預後不良的徵兆,故敗血症不要等到發熱才做血培養;支氣管肺炎伴低溫症時常是先由其他原因引起低溫症後誘發支氣管肺炎。
②內分泌疾病:黏液性水腫和垂體功能低下因熱量產生不足而出現低溫症時,其病死率明顯增高。脂肪瀉所致的低溫症也可能與垂體功能低下有關。糖尿病致低溫症的危險性比非糖尿病高6倍,這可能與自主神經周圍神經和血管等病變有關低血糖患者50%可出現低溫症,可以此作為重要診斷線索。以便迅速給予葡萄糖治療。尿崩症和艾迪生病亦可引起體溫過低。
③中樞神經和運動系統疾病:腦血管意外、蛛網膜下腔出血、硬腦膜下血腫、腦瘤、顱外傷和脊髓損傷等疾患均能擾亂下丘腦體溫調節而致低溫症其中Wernicke氏出血性腦病(急性出血性腦灰質炎)尤其值得注意這是一種由於酒精中毒引起的維生素B缺乏症,特徵是在第三腦室、延腦及乳頭狀體上有出血性病變,如果患者出現低溫而未及時想到本病,就會失去套用硫胺素治療的機會,使本來容易治療的疾病惡化。許多神經和運動系統疾患可因活動受限制、熱量產生不足而致低溫症。帕金森病則是由於自主功能紊亂引起低溫症。跌倒也是引起本病的原因之一,老年人夜間上廁所跌倒時,可能因無力爬起而長時間躺在地板上,導致體熱大量喪失引起體溫過低。
④藥物和酒:藥物的使用是造成大量體溫過低的一個原因許多藥物如鎮靜、苯甲二氮、抗抑鬱藥以及酒精等均可抑制中樞和外周的體溫調節機制而引起低溫症。用藥的人可以感到寒冷又無法使自己暖和起來,寒戰也可能被抑制了。最可能引起體溫過低的藥物,包括吩噻嗪類抗精神病藥、三環類抗抑鬱藥、苯甲二氮類和巴比妥類鎮靜催眠藥、麻醉劑等,如氯丙嗪能抑制發抖,是最熟知的降溫藥。大量飲酒不僅抑制體溫調節中樞,而且通過擴張周圍血管導致體溫過低。
⑤精神因素:精神錯亂和痴呆可能缺乏對寒冷的警覺,常伴有體溫調節功能障礙,加之套用精神病治療藥物以致誘發低溫症抑鬱,特別是喪失親人後的抑鬱是促使體溫過低的一個常見原因,他們的生活勇氣受到挫折,可能拒絕吃、喝取暖。此外,抗抑鬱藥常抑制顫抖並可能進一步加重體溫過低。
⑥其他疾病:營養不良和惡病質也是老年人繼發性低溫症的重要原因。燒傷、剝脫性皮炎和Paget氏病等可因皮膚損傷、體表血管分布增多,使體熱大量丟失而導致低溫症。急性心肌梗死和肺栓塞等均能引起體溫調節機制的急性紊亂。尿失禁也易促使體溫過低,一則散熱;二則當尿與身體接觸時,使身體變涼。
總之,導致老年低溫症的原因是多方面的,大致可歸納為3大類:
A.社會因素:
a.孤獨生活。
b.大量飲酒。
c.環境溫度低
B.身體因素:
a.內分泌疾病
b.神經系統疾病。
c.運動系統疾病。
d.心血管疾病。
e.呼吸系統疾病。
f.胃腸道疾病
g.慢性消耗性疾病。
h.醫源性疾病。
i.跌倒。
j.重症感染。
k.老化。
C.精神因素:
a.抑鬱症。
b.精神錯亂。
c.痴呆。
發病機制老年低溫症發病機制尚未闡明。一般認為,體溫調節生理功能障礙和伴隨的各種基礎疾病及降低熱能產生的藥物是老年人低溫症的重要原因。
臨床表現
 老年低溫症
老年低溫症1.外貌 由於面部出現蒼白和發紺的混合表現,患者面色灰白,有時呈特異粉紅色而疑為一氧化碳中毒。皮膚發涼。面部虛腫、講話遲鈍和聲音嘶啞可誤診為黏液性水腫。當患者體溫恢復正常時上述症狀消失。
2.中樞神經系統 輕度低溫症時出現寒戰,中樞神經系統呈現共濟失調、痴呆發音障礙或緩慢,幻覺改變等,常被誤認為是“衰老”所致體溫<32℃時,寒戰消失,反射遲鈍代以肌張力增強,並出現譫妄和昏睡。體溫<25℃時,病人呈昏迷,反射消失,兩側瞳孔大小不等,對光反應微弱。
3.呼吸系統 開始因呼吸中樞抑制不明顯,症狀很少。隨著體溫下降,呼吸變緩變淺,通氣呈現不足。肺底出現的囉音不完全是由於感染,有可能是有肺水腫。由於精神錯亂、咳嗽反射減弱以及寒冷對支氣管肺臟的刺激,致使分泌增加,痰液排除困難,可導致吸入性肺炎、肺水腫、繼發性感染和肺不張,後者可聞及捻發音。低溫症時血紅蛋白氧離曲線左移使組織水平的氧釋放減少,出現無氧代謝增加和呼吸換氣減少,從而導致嚴重呼吸性酸中毒,終致呼吸衰竭。
4.心血管系統 常見心排血量減少、低血壓、心動過緩和心房顫動。如果出現心動過速應想到低血糖性低溫症。心電圖常呈不同程度的傳導阻滯,並可出現室內傳導延遲,亦可出現各種形式的心律失常,包括心房顫動、心房撲動、室性期前收縮和室性自主節律更為常見的心電圖改變是細小規則的基線擺動,這是由覺察不出顫抖的肌張力增加所形成。體溫<32℃時1/3患者可在QRS波終末與ST段聯結處出現特徵性的曲折—-—“J”波(Osbom波)於左心前導聯上尤其明顯,呈正性波,而右側則呈負性,雖無預後意義但它僅在低溫症時出現。體溫<28℃可出現室顫,最終可致心臟停搏。
5.泌尿系統 低溫症患者由於缺血加上寒冷對腎臟的直接損害,可發生少尿和急性腎小管壞死。早期由於腎小管活動減退,也可出現“寒冷性多尿”,導致低血容量和腎前性氮質血症。
6.消化系統 常出現急性胰腺炎和腮腺炎,前者往往缺少體徵,僅有血清澱粉酶升高如用力壓迫上腹部患者出現畏縮者應疑及本病。胃腸道功能常發生障礙,蠕動減弱,出現麻痹性腸梗阻和消化道出血,腹氣脹和腸鳴音減弱。肝功能受損時血液pH值下降,肝臟解毒能力低下。
7.血液系統 血濃縮血液黏性增加血小板減少,並可發生DIC
8.內分泌系統 由於胰島素釋放減少和效應減退使葡萄糖利用減少,可出現高血糖症。腎上腺皮質受損可誤診為艾迪生病,但當體溫回升後症狀消失。甲狀腺和垂體功能均有不同程度損害。
併發症最常見的併發症有胰腺炎肺水腫肺炎、代謝性酸中毒、腎衰竭及肢體壞疽。
診斷
細胞圖
細胞圖判斷引起低溫症的各種原發疾病也很難,應高度警惕由於甲狀腺功能低下症、糖尿病、心肌梗死、支氣管肺炎以及中樞神經系統疾患合併繼發性低溫症。對無明顯原因可查的低溫症患者,特別是處於昏迷狀態者應測定血漿和尿中有無導致低溫症的藥物。
檢查
 檢查
檢查體溫過低的多數實驗室數據是非特異的檢查包括白細胞、血小板計數,凝血酶原時間、纖維蛋白原、血糖、血清澱粉酶、血尿素氮、血清穀草轉氨酶、a-J羥酸脫氫酶(HBD)和肌酸磷酸激酶(CPK)腎功能以及動脈血氣分析等如發現血小板減少,血尿素氮、血清澱粉酶和上述其他酶類水平增高應想到本病此外套用放免法測定血清三碘甲狀腺氨酸(T3)、甲狀腺素(T4)以及促甲狀腺素(TSH)水平,可以診斷為原發性黏液水腫所致低溫症,本病血清T3、T4水平下降而TSH升高,非黏液性水腫所致的低溫症則尚不能達到這一程度。
其它輔助檢查:
心電圖常呈不同程度的傳導阻滯並可出現室內傳導延遲。
相關檢查: T3 T4 促甲狀腺刺激激素 尿素 澱粉酶 纖維蛋白原 肌酸激酶 血小板 血氣分析
治療
 復溫方法
復溫方法2.復溫方法 低溫症患者的復溫方法見表1,對低溫患者施以何種復溫方法為好,仍有爭論。健康年輕人因淹溺於冷水中或暴露於寒冷環境所致的原發性意外性低溫症,可用標準的快速體外復溫法進行治療,但這種方法不適應於老年患者,因其常能誘發心律失常循環虛脫、致死性低血壓以及體內溫度續降等危險。而且,目前認識到積極的體內加溫法亦有致體內溫度續降之弊端。所以老年患者通常適用於保守復溫法,即將患者移至室溫25℃左右的病房內,身體蓋以乾潔衣被或毛毯使其體溫慢慢回升0.5~0.81℃/h,用這種方法即使患者體內溫度<28℃也常可奏效,如果達不到上述復溫速度,則提示可能為繼發性低溫症。可是,如果患者處於寒冷環境的時間已久,這種保守的緩慢復溫方法可能使機體組織發生不可逆性改變。所以,Exton-Smith推薦表2所列綜合治療方法,作為大多數意外性低溫症患者的處理方法,可結合具體情況靈活掌握實施。
對策
1.添加保暖衣物
寒冬季節,即使是在家中,也有可能感到寒冷,尤其是氣溫驟降的深夜,因此隨時適時添加衣物是很重要的。
在衣物的選擇方面,以舒適、輕便、透氣度佳、保暖性高的質料為優,並且要合身,太過松垮或是緊繃的衣物,都會讓保暖機能降低。
除了身體之外,也別忘了頭、頸、手、腳部位的保暖。
有些人會在家中使用電暖爐來保持室內溫度,這確實是禦寒的好方法,但應該確保室內的空氣流通,並且遠離易燃物品,以避免發生火警或是灼傷的危險。
至於患有糖尿病及脊髓問題病患者,因為本身對於熱能知覺較不敏銳,所以最好不要使用如暖暖包、電熱毯等貼身暖物,以免造成燙傷而不自覺。
2.減少熱量流失
穿著濕冷的衣物,或是長時間浸泡在水裡,會讓身體的熱能迅速流失,因此即使是在運動過後,身體會產生大量的熱能,但如果穿著被汗水浸濕衣服,也有可能會造成失溫現象。
此外,游泳前一定要做好暖身運動才下水,游泳過後也要立即擦乾身體,換上乾爽保暖的衣物,以免身體中的熱能急速被消耗殆盡。
酒精飲品雖然會讓人感覺溫暖,但其實會使血管急速擴張,加快熱量的發散,因此造成體溫下降,所以千萬別相信在寒冬中飲酒可以驅寒暖身的錯誤說法。
3.提高體內製造能量機場能
除了靠外在的力量來保暖之外,提高自體體溫才是最積極的方法,例如保持運動習慣,能夠加強血液循環與新陳代謝機能;維持營養均衡,身體才有足夠的能量來提供所需的熱能,尤其是維他命E、C含量豐富的食物,如青背魚、黃綠色蔬菜、豆類、柑橘、花椰菜,青椒、薯類等應多多攝取,高熱量易吸收的食物,也能迅速幫身體加溫,不過還是要避免高油脂、高膽固醇,以免過了一個寒冬,不但體重增加,健康風險也跟著增高了。
自救方法
出現嚴重的失溫現象時,最安全的方式,便是送醫急救,但如果無法緊急就醫,就得要學會自救的方法!
保持冷靜:這是首要條件。緊張不安的心理,會讓身體循環、心跳加速,因而失去更多熱能。
讓身體維持乾爽:濕透的衣物會讓散熱速度加倍,須儘速更換乾燥的衣物,或是想辦法將身體弄乾。
從身體中央開始加溫:雖然手腳最容易感到冰冷,但要讓體溫上升最快的方式,應先溫暖身體的中央部位。
縮小身體的散熱範圍:如果是不幸遇上海難等情況,必須浸泡在水中等待救援,最好是儘量將身體縮起來,雙手抱於胸前,以便減緩熱能流失的速度。
飲用酒精之外的溫飲品:在意識清醒的狀態下,飲用溫度適中的飲料可以迅速幫身體加溫,但由於低溫患者對於熱能知覺反應較低,所以過燙的熱飲可能很容易造成燙傷傷害。
預後預防
預後:
許多低溫症患者經合理復溫搶救可在12~24h恢復正常體溫,但預後取決於低溫症的嚴重程度持續時間以及基礎疾病的性質。深部溫度越低、病死率越高;受凍和低溫持續的時間越長,代謝障礙就越嚴重,容易發生併發症;基礎疾病對預後也有影響,特別是老年人常並存各種疾病,如果誘發低溫症的疾病是可以恢復或是能夠治療的,預後好,反之則預後差。
預防:
老年人應合理營養、科學膳食增加熱量、注意保暖,有基礎疾病應積極治療和康復。
二不一防
冬季是個特殊的季節,日照短、氣溫低,老年人安全過冬,應採取相應的措施,以下“二不”“一防”就是老年人冬季應該做到的。
不戀床:老人睡眠不足,會影響健康,但睡眠時間過長,同樣不利於健康。生理學家認為,60至70歲的老人每天睡眠6至7小時為宜,70歲以上的高齡老人
每天睡眠一般不宜超過6小時。這是因為,老人睡眠時間越長,體能下降越多,進而加速身心老化。調查證實,凡每天睡眠時間超過9小時的老人,不僅沒有顯出精力充沛,反而情緒低落、動作笨拙,出現反常心理,且可能變得愈睡愈懶。老人容易產生疲勞感,專家建議應儘量避免以消極的睡眠方式休息,而應採取散步、聊天、遊玩、娛樂等較為積極的方式休息。這不僅會使身體很快得到放鬆和恢復,而且會使身體得到鍛鍊,延緩衰老。
不抑鬱:老年人冬季極易抑鬱。造成冬季抑鬱症的病因主要是冬季陽光照射少,人體生物鐘不適應日照時間縮短的變化,導致生理節律紊亂和內分泌失調。據有關資料表明,老人尤其是體質較差或極少參加體育鍛鍊的腦力勞動者,以及平時對寒冷較敏感者,比一般人更容易產生冬季抑鬱症。防治冬季抑鬱症,首先,要改善居室光照環境。拉開窗簾,牆壁塗上鮮明的色彩,安裝較亮的燈泡等,可使情緒放鬆,如遷新居應選擇光照好的房間。其次,要吃一些能提高情緒的食品,如粗糧、麵包、牛肉、香蕉、柑橘、朱古力和咖啡等,使影響人們情緒、智慧型、行為的化學物質的含量增高。第三,多到戶外去活動。通過戶外鍛鍊可減輕抑鬱情緒。早上散步1小時可使抑鬱情緒得到更大的緩解。
防低體溫症:寒氣逼人的嚴冬,低體溫症對老年人是一個較大的威脅。醫學上將老人體溫持續在35℃(肛門內溫度)以下稱為“低體溫症”。其發生機理是老人機體老化,體內產熱減少,皮膚血管不能很好地收縮,丟失的熱量也比較大,因而不能使體溫維持在正常水平。低體溫症輕度表現為嗜睡、無精打采,重度表現為神志模糊,面呈灰色,還可能發生紫癜或水皰,面部腫脹,甚至意識障礙,呼吸、心跳減慢等,如不及時採取措施,則有生命危險。不少老年人因患“冬季低溫症”而死亡,調查表明,60歲以上的老人在氣候惡劣的冬季,死亡率要比氣候正常的冬季高60%。預防老人冬季低體溫症,首先要注意保暖,準備充足的禦寒衣被,居室溫度最好保持在20℃左右,晚上也應採取一些保暖措施,使用電熱毯、熱水袋等;其次,要鼓勵老人冬季多參加一些體育活動。此外,老人冬季在飲食方面應多進食些高熱量的食物,如栗子、胡桃肉、鱔魚、蝦、羊肉、狗肉、豬肝、雞肉、豬肚、火腿等,但不宜多飲酒。一旦發現老人有低體溫症時,應迅速送醫院急診。
